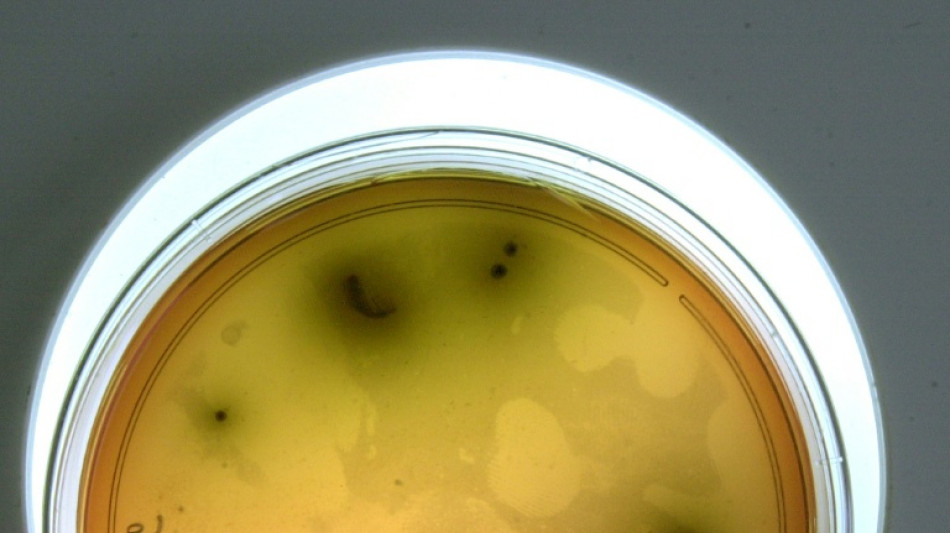
R&uuml;ckruf von Lebensmitteln: Listerien sind h&auml;ufigste Ursache

Rückruf von Lebensmitteln: Listerien sind häufigste Ursache
Im Jahr 2025 sind über das Portal lebensmittelwarnung.de insgesamt 323 Rückrufe veröffentlicht worden, 13 Fälle mehr als im Vorjahr. Wie das Bundesamt für Verbraucherschutz und Lebensmittelsicherheit (BVL) am Donnerstag mitteilte, waren bei knapp einem Drittel der Rückrufe Krankheitserreger der Grund. Listerien waren demnach mit 43 Meldungen die häufigste Ursache, gefolgt von Salmonellen (27). Beide Bakterien können schwere Erkrankungen auslösen.
"In den Vorjahren lagen Salmonellen in der Liste der Krankheitserreger vorn, die zu Lebensmittelrückrufen geführt haben", erklärte BVL-Präsidentin Gaby-Fleur Böl. "Seit dem Jahr 2024 stehen nun Listerien an der Spitze dieser Liste."
Während gesunde Menschen eine Listerieninfektion nach BVL-Angaben "in der Regel nicht bemerken", können die Bakterien vor allem bei abwehrgeschwächten Menschen und bei Schwangeren zu schweren Krankheitsverläufen führen und sich auch im Kühlschrank weiter vermehren. Höhere Temperaturen wie beim Kochen, Frittieren oder Grillen töten die Bakterien ab.
Das Portal lebensmittelwarnung.de ist die offizielle Plattform, auf der die zuständigen Behörden der 16 Bundesländer und das BVL Informationen zu Produkten veröffentlichen, die möglicherweise gesundheitsgefährdend oder aus anderen Gründen für den Verzehr oder Gebrauch ungeeignet sind. Gründe für Rückrufe im vergangenen Jahr waren neben Krankheitserregern unter anderem auch Allergene und Fremdkörper. 90 Prozent der Rückrufe betrafen Lebensmittel; auf Bedarfsgegenstände wie Kleidung, Spielwaren oder Lebensmittelverpackungen entfielen rund 7,5 Prozent der Meldungen, auf kosmetische Mittel knapp 2,5 Prozent.
C.Weber--BlnAP

 Berlin
Berlin

 München
München
 Hamburg
Hamburg
 Düsseldorf
Düsseldorf
 Frankfurt am Main
Frankfurt am Main
 Potsdam
Potsdam
 Leipzig
Leipzig
 Dortmund
Dortmund
 Hannover
Hannover
 Köln
Köln
 Kiel
Kiel
 Bremen
Bremen
 Flensburg
Flensburg
 Rostock
Rostock



